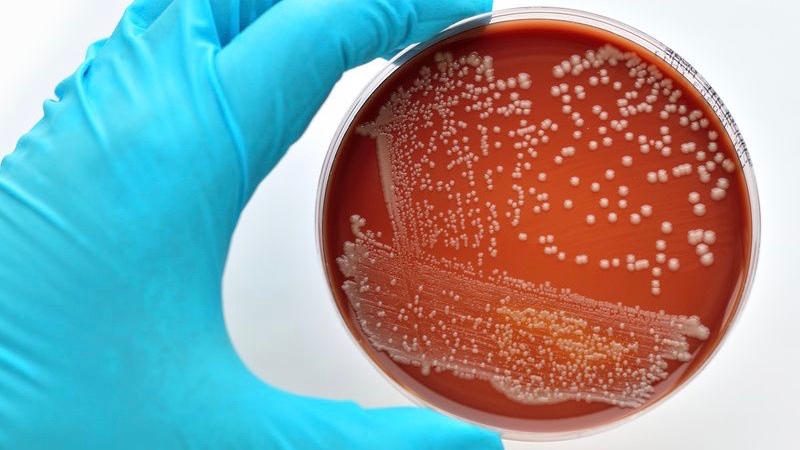
Labor Bakterienkultur eines Streptokokken-Test

Tipps
Unsere Tipps für den Umgang mit IGeL-Angeboten.
weiterlesen
Kann der Test dazu beitragen, dass sich weniger Neugeborene mit B-Streptokokken anstecken?
Bild: Jarun Ontakrai/Shutterstock
Bild: Jarun Ontakrai/Shutterstock | Fachgebiet | Frauenheilkunde und Geburtshilfe |
|---|---|
| Bereich | Schwangerschaft und Geburt |
| Anlass |
mögliche Infektion mit B-Streptokokken |
| Verfahren |
vaginaler und analer Abstrich, Labortest |
| Kosten |
10 bis 30 Euro |
| GKV-Leistung |
Diverse Untersuchungen, Beratungen, Betreuungen und Behandlungen von Schwangeren, Streptokokken-Test bei Verdacht auf Infektion |
Wir bewerten den Streptokokken-Test bei Schwangeren mit „unklar“.
Bei vielen Schwangeren ist die Vagina mit Bakterien vom Typ B-Streptokokken besiedelt. Für gesunde Schwangere ist das meist nicht problematisch, aber den Babys droht Gefahr: In seltenen Fällen können sich die Babys rund um die Geburt mit den Bakterien anstecken. Das kann schlimme Folgen haben, wie eine Blutvergiftung oder eine Gehirnhautentzündung. Damit Schwangere ihr Baby nicht anstecken, bekommen sie kurz vor der Geburt Antibiotika. Ob eine Schwangere Antibiotika bekommen sollte, wird mit einer von zwei Strategien ermittelt: entweder dadurch, dass ein Labortest eine Besiedlung mit B-Streptokokken nachgewiesen hat (Test-Strategie), oder dadurch, dass das Risiko einer Ansteckung besonders hoch ist (Risiko-Strategie). Bei hohem Risiko wird oft zusätzlich noch ein B-Streptokokken-Test gemacht, der dann Kassenleistung ist. Bei normalem Risiko ist der Test jedoch eine IGeL. Er kostet in der Regel zwischen 10 und 30 Euro.
Das wissenschaftliche Team des IGeL-Monitors wollte herausfinden, ob die Test- oder die Risiko-Strategie besser ist. Für so eine Bewertung müssen jeweils Nutzen und Schaden berücksichtigt werden: Nützlicher wäre die Strategie, bei der sich weniger Neugeborene anstecken, schädlicher wäre die Strategie, bei der mehr Frauen unnötigerweise Antibiotika bekommen. Es fanden sich ein Dutzend Studien, die jedoch zu unterschiedlichen Ergebnissen kamen. Manche Studien fanden heraus, dass der Test Babys schützen kann, andere Studien sahen diese Vorteile nicht. Nur drei der Studien nannten Zahlen zu den Antibiotika-Einnahmen. Es zeigte sich, dass mit der Test-Strategie häufiger Antibiotika gegeben werden als mit der Risiko-Strategie. Insgesamt sehen wir deshalb Hinweise darauf, dass die Test-Strategie zwar etwas mehr Nutzen, aber auch etwas mehr Schaden mit sich bringt als die Risiko-Strategie. Nutzen und Schaden halten sich unserer Meinung nach die Waage und wir bewerten die IGeL „Streptokokken-Test in der Schwangerschaft“ deshalb mit „unklar“.
Erstellt am:
Letzte Aktualisierung:
Bild: Jarun Ontakrai/Shutterstock
https://igel-monitor.de/igel-a-z/igel/show/streptokokken-test-in-der-schwangerschaft.html
| Fachgebiet | Frauenheilkunde und Geburtshilfe |
|---|---|
| Bereich | Schwangerschaft und Geburt |
| Anlass |
mögliche Infektion mit B-Streptokokken |
| Verfahren |
vaginaler und analer Abstrich, Labortest |
| Kosten |
10 bis 30 Euro |
| GKV-Leistung |
Diverse Untersuchungen, Beratungen, Betreuungen und Behandlungen von Schwangeren, Streptokokken-Test bei Verdacht auf Infektion |
Wenn Schwangere Bakterien vom Typ B-Streptokokken in sich tragen, können sich ihre Babys kurz vor oder während der Geburt bei ihnen anstecken. Dies kann beim Neugeborenen unter anderem zu Blutvergiftung, Lungenentzündung, Gehirnhautentzündung oder sogar zum Tod führen. Obwohl 16 Prozent aller Schwangeren in Deutschland den Erreger in sich tragen, erkranken oder sterben Neugeborene äußerst selten aufgrund von Streptokokken-Infektion. Eine mögliche Maßnahme, Neugeborene vor den Bakterien zu schützen, besteht darin, Schwangere kurz vor der Geburt mit Antibiotika zu behandeln. Ob die Schwangeren mit B-Streptokokken besiedelt sind, wird mit einem vaginalen und rektalen Abstrich festgestellt, der im Labor auf die Bakterien getestet wird. Krankenkassen bezahlen umfangreiche Maßnahmen zum Schutz von Schwangeren und Neugeborenen. Ein Streptokokken-Test ist dann Kassenleistung, wenn bei einer Schwangeren ein Verdacht auf eine Scheidenbesiedlung besteht oder wenn sie zum Beispiel schon einmal eine Frühgeburt hatte und deshalb ihr Risiko erhöht ist. Ohne solche Gründe ist der Test jedoch eine IGeL. Der Test kostet in der Regel zwischen 10 und 30 Euro.
Bei fast jeder Frau ist die Schleimhaut der Vagina mit Bakterien besiedelt. Diese natürliche Besiedlung wird Scheidenflora genannt. Sie hindert krankmachende Erreger daran, sich auszubreiten. B-Streptokokken, die ebenfalls häufig bei Frauen in der Scheide vorkommen, gehören zu den Erregern, die Krankheiten auslösen können. Für gesunde Frauen ist diese Besiedelung meist unproblematisch. Gefahr droht jedoch dann, wenn Frauen schwanger sind und die Scheide und eventuell auch das Fruchtwasser mit den Bakterien besiedelt sind.
Wenn sich Neugeboren mit B-Streptokokken angesteckt haben, unterscheidet man zwischen einer frühen Form (early-onset) und einer späten Form (late-onset). Als frühe Form werden Infektionen bezeichnet, die sich in den ersten sieben Tagen nach der Geburt durch Krankheitsanzeichen bemerkbar machen. Bei der frühen Form stecken sich die Babys meist bereits in der Gebärmutter über das besiedelte Fruchtwasser an. Erste Symptome zeigen sich daher in der Regel innerhalb von 20 Stunden nach der Geburt. Als späte Form gelten Infektionen, die sich zwischen sieben Tagen und drei Monaten nach der Geburt bemerkbar machen. Die Übertragung der Erreger findet bei der späten Form selten vor oder während der Geburt statt, sondern meist erst nach der Geburt durch eine sogenannte Schmierinfektion, zum Beispiel über verunreinigte Hände. Aus diesem Grund kann die Maßnahme, dass Schwangere vor der Geburt Antibiotika einnehmen, nur die Gefahr der frühen Form verringern.
Eine Übertragung der Bakterien von der Mutter auf das Baby und eine Erkrankung des Neugeborenen sind sehr selten: Bei 715.000 Geburten im Jahr 2014 in Deutschland sind vermutlich mehr als 100.000 Frauen mit B-Streptokokken infiziert. Es gab etwas mehr als 100 Infektionen bei Neugeborenen, dabei waren etwa 60 Prozent von der frühen Form und 40 Prozent von der späten Form. Die häufigsten Folgen für die Neugeborenen sind Blutvergiftung bis hin zum septischen Schock sowie Gehirnhaut- und Lungenentzündung, seltener sind Knochenmarks- und Gelenkentzündungen. Etwa jedes dreißigste infizierte Neugeborene stirbt an den Folgen der Infektion.
Für den Schwangeren-Test auf B-Streptokokken wird zwischen der 35. und 37. Schwangerschaftswoche ein Abstrich von der Vagina und dem letzten Stück des Enddarms genommen. Anschließend werden im Labor aus dem Abstrich Bakterien angezüchtet und bestimmt. Wenn B-Streptokokken gefunden werden, wird der Schwangeren dringend eine Antibiotika-Behandlung zur Geburt empfohlen.
Alternativ zum Testen der Schwangeren wird die Strategie des so genannten risikobasierten Managements verfolgt. Dabei bekommen Schwangere immer dann Antibiotika, wenn beispielsweise eine Frühgeburt akut droht, ein früheres Kind infiziert war, seit einem vorzeitigen Blasensprung mehr als 18 Stunden vergangen sind oder die Mutter bei der Geburt eine erhöhte Temperatur von über 38 Grad hat. Oft wird dann zusätzlich noch ein Bakterien-Test gemacht und nur bei einem positiven Befund werden Antibiotika gegeben. In manchen Fällen, etwa bei einer Infektion eines früheren Babys oder wenn die Zeit für einen Test nicht mehr reicht, werden Antibiotika auch ohne Test gegeben.
Eine Befragung von knapp 1.300 Versicherten der Barmer GEK durch die Bertelsmann Stiftung im Jahr 2014 ergab, dass etwa 85 Prozent der Schwangeren ein B-Streptokokkentest angeboten wurde. 75 Prozent nahmen ihn in Anspruch, 10 Prozent lehnten ihn ab. Man kann also davon ausgehen, dass ein Großteil der Schwangeren den Test, und ein kleinerer Teil das risikobasierte Management bekommt.
Um Nutzen und Schaden des Streptokokken-Tests in der Schwangerschaft zu beurteilen, ist es deshalb sinnvoll, die Folgen einer Antibiotika-Behandlung aufgrund eines positiven Tests mit den Folgen einer Antibiotika-Behandlung aufgrund eines risikobasierten Managements zu vergleichen. Es geht bei der Beurteilung der IGeL demnach nicht um die Frage, wie die Folgen einer Antibiotika-Behandlung verglichen mit den Folgen keiner Antibiotika-Behandlung wären, da dieser Vergleich für die Praxis in Deutschland kaum eine Rolle spielt.
Es wurden insgesamt vier internationale Leitlinien gefunden. Eine aktuelle Leitlinie deutscher Fachgesellschaften vom März 2016 empfiehlt, alle Schwangeren zwischen der 35. und 37. Schwangerschaftswoche auf B-Streptokokken zu testen und infizierte Frauen bei der Geburt mit Antibiotika zu behandeln. Dafür soll ein kombinierter Abstrich von Vagina und Anus verwendet und eine mögliche Besiedelung mithilfe einer Laborkultur bestimmt werden. Die Leitlinie rät von einem Gebärmutterhalsabstrich ebenso ab wie von einem Schnelltest. Allerdings liegt diesen Empfehlungen keine systematische Literaturrecherche zugrunde.
Eine kanadische Leitlinie kommt zu einem ähnlichen Schluss, während zwei englische Leitlinien den Test nicht empfehlen.
Auch die Praxis wird verschieden gehandhabt. In England und Holland wird das risikobasierte Management bevorzugt, während den USA, in Kanada und in vielen europäischen Ländern getestet wird. In Deutschland gibt es keine organisierte, kassenfinanzierte Routineuntersuchung, aber manche Kliniken und auch Geburtshäuser fordern den Test, entweder für alle Frauen oder für bestimmte Geburtsarten, wie etwa einer Wassergeburt.
Der B-Streptokokken-Test in der Schwangerschaft wäre nützlich, wenn er dem risikobasierten Management überlegen wäre, und zwar indem er dazu beitragen würde, mehr Infektionen von Neugeborenen samt Folgen zu verhindern als mithilfe des risikobasierten Managements verhindert werden könnten.
Es fanden sich zwei Übersichtsarbeiten , die der Frage nachgegangen sind, welche der beiden Strategien besser ist. Beide Übersichtsarbeiten werteten insgesamt 12 verschiedene Einzelstudien aus. Die Ergebnisse der Einzelstudien fielen unterschiedlich aus: Manche sahen den Test als überlegen, manche sahen beide Strategien als gleichwertig an. Auch die Übersichtsarbeiten zogen diese konträren Schlüsse: Die eine sah die Test-Strategie klar im Vorteil, die andere sah beide als gleichwertig an.
Insgesamt ist die Datenlage schwach, da keine der Einzelstudien hohen Qualitätsansprüchen genügt, weshalb sie nicht sehr aussagekräftig sind. Dennoch sehen wir unter dem Strich Hinweise auf einen Nutzen des B-Streptokokken-Tests im Vergleich zum risikobasierten Management.
Der B-Streptokokken-Test in der Schwangerschaft wäre schädlich, wenn er dazu beitragen würde, dass mehr Frauen unnötigerweise Antibiotika bekommen und sie und/oder ihr Baby dadurch geschädigt werden, als das mithilfe des risikobasierten Managements der Fall wäre.
Nur drei der Einzelstudien berichten, wie viele Frauen jeweils mit Antibiotika behandelt wurden. Ergebnis: Etwa jede vierte Frau, die auf B-Streptokokken getestet wurde, bekam Antibiotika, aber nur jede fünfte Frau, die nach einem risikobasierte Management behandelt wurde. Da sich nur ein Bruchteil der Babys bei der Mutter ansteckt, ist der weit überwiegende Anteil der Antibiotika-Gaben unnötig. Die Einnahme von Antibiotika kann bei der Schwangeren gelegentlich unangenehme bis selten gefährliche Folgen haben, wie etwa allergische Reaktionen.
Bekommt die Schwangere vor der Geburt Antibiotika, gelangen diese über die Placenta auch in den Blutkreislauf des Babys. Man weiß nichts darüber, ob die Antibiotika bei den Neugeborenen langfristig negative Folgen haben könnten.
Insgesamt sehen wir deshalb Hinweise auf mögliche Schäden des B-Streptokokken-Tests im Vergleich zum risikobasierten Management.
Wir bewerten den B-Streptokokken-Test in der Schwangerschaft mit „unklar“. Nutzen und Schaden halten sich unserer Ansicht nach die Waage. Eine insgesamt schwache Datenlage lässt darauf schließen, dass es sowohl Hinweise auf einen Nutzen als auch auf einen Schaden gibt: Wir sehen Hinweise darauf, dass sich weniger Neugeborene anstecken und krank werden, wenn ihre Mütter getestet werden, als wenn sie mit einem risikobasierten Management behandelt werden. Wir sehen aber auch Hinweise darauf, dass mehr Mütter unnötig Antibiotika bekommen, wenn sie getestet werden.
An der schwachen Datenlage wird sich vermutlich nichts mehr ändern. Wie die deutschen Fachgesellschaften in ihrer Leitlinie schreiben, würden hochwertige Studien heute als unethisch angesehen und deshalb abgelehnt werden.
Erstellt am:
Letzte Aktualisierung:
Bild: Jarun Ontakrai/Shutterstock
https://igel-monitor.de/igel-a-z/igel/show/streptokokken-test-in-der-schwangerschaft.html
Download: Merkblatt herunterladen
190 KB | PDF-Dokument
Hinweis: Diese PDF ist nicht barrierefrei
Erstellt am:
Letzte Aktualisierung:
Bild: Jarun Ontakrai/Shutterstock
Erklärung der Bewertung: positiv: Unserer Ansicht nach wiegt der Nutzen der IGeL deutlich schwerer als ihr Schaden
Erklärung der Bewertung: tendenziell positiv: Unserer Ansicht nach wiegt der Nutzen der IGeL geringfügig schwerer als ihr Schaden
Erklärung der Bewertung: unklar: Unserer Ansicht nach sind Nutzen und Schaden der IGeL ausgewogen, oder wir finden keine ausreichenden Daten, um Nutzen und Schaden zu beurteilen
Erklärung der Bewertung: tendenziell negativ: Unserer Ansicht nach wiegt der Schaden der IGeL geringfügig schwerer als ihr Nutzen
Erklärung der Bewertung: negativ: Unserer Ansicht nach wiegt der Schaden der IGeL deutlich schwerer als ihr Nutzen
Erklärung der Bewertung:
Wir verwenden Cookies, um Ihnen die optimale Nutzung unserer Webseite zu ermöglichen. Es werden für den Betrieb der Seite notwendige Cookies gesetzt. Mit Ihrer Zustimmung zu Statistik-Cookies helfen Sie uns, die Nutzung dieser Webseite zu analysieren und unser Angebot laufend zu verbessern. Dafür setzen wir Matomo ein, dass die erfassten Daten automatisch anonymisiert. Erfahren Sie mehr dazu in unserer Datenschutzerklärung.
„GKV“ steht für die Gesetzliche Krankenversicherung in Deutschland. Alle Arbeitnehmerinnen und Arbeitnehmer, deren Gehalt eine bestimmte Obergrenze nicht überschreitet, müssen sich in ihr versichern
"Ärztinnen und Ärzte sind je nach Spezialisierung in „Fachgesellschaften“ organisiert. Anders als die Verbände oder Genossenschaften, die die Interessen der Ärztinnen und Ärzte vertreten, bemühen sich die Fachgesellschaften um das bestmögliche und aktuellste medizinische Wissen und geben es auf Tagungen oder in Leitlinien an Kolleginnen und Kollegen der jeweiligen Fachrichtung sowie an Patientinnen und Patienten weiter. Übergeordnete Einrichtungen sind etwa die AWMF.
"Ärztinnen und Ärzte sind je nach Spezialisierung in „Fachgesellschaften“ organisiert. Anders als die Verbände oder Genossenschaften, die die Interessen der Ärztinnen und Ärzte vertreten, bemühen sich die Fachgesellschaften um das bestmögliche und aktuellste medizinische Wissen und geben es auf Tagungen oder in Leitlinien an Kolleginnen und Kollegen der jeweiligen Fachrichtung sowie an Patientinnen und Patienten weiter. Übergeordnete Einrichtungen sind etwa die AWMF.
"„GKV“ steht für die Gesetzliche Krankenversicherung in Deutschland. Alle Arbeitnehmerinnen und Arbeitnehmer, deren Gehalt eine bestimmte Obergrenze nicht überschreitet, müssen sich in ihr versichern
"Eine „Leitlinie“ ist eine unverbindliche Handlungsanweisung für Ärztinnen und Ärzte, zum Teil auch für Patientinnen und Patienten. Man unterscheidet je nach wissenschaftlichem Aufwand S1-, S2- und S3-Leitlinien. Das Erstellen von Leitlinien wird von den medizinischen Fachgesellschaften organisiert.
"Eine „Leitlinie“ ist eine unverbindliche Handlungsanweisung für Ärztinnen und Ärzte, zum Teil auch für Patientinnen und Patienten. Man unterscheidet je nach wissenschaftlichem Aufwand S1-, S2- und S3-Leitlinien. Das Erstellen von Leitlinien wird von den medizinischen Fachgesellschaften organisiert.
"Der Medizinische Dienst Bund betreibt den IGeL-Monitor. Er wurde zum 1. Januar 2022 als Nachfolger des Medizinischen Dienstes des Spitzenverbandes Bund der Krankenkassen e.V. (MDS) errichtet und ist eine medizinische und pflegefachliche Expertenorganisation in der Trägerschaft der 15 Medizinischen Dienste in den Ländern.
"Mit „Nutzen“ ist gemeint, ob und wie sehr ein Test oder eine
Behandlungsmethode Patientinnen und Patienten nützt, indem etwa ihre Lebensqualität erhöht oder ihr Leben verlängert wird. Wir unterscheiden
„geringen“ und „erheblichen“ Nutzen, wobei sowohl Größe als auch
Häufigkeit des Nutzens berücksichtigt werden.
"Mit „Schaden“ ist gemeint, ob und wie sehr eine Untersuchung oder eine Behandlung Patientinnen und Patienten schadet, indem etwa ihre Lebensqualität verringert oder ihr Leben verkürzt wird. Wir unterscheiden „geringen“ und „erheblichen“ Schaden, wobei dabei sowohl Größe als auch Häufigkeit des Schadens berücksichtigt werden. Bei Vorsorge-, Früherkennungsuntersuchungen und invasiven Behandlungen gehen wir auch ohne Studien grundsätzlich von „Hinweisen auf einen geringen Schaden“ aus.
"Mit „Schaden“ ist gemeint, ob und wie sehr eine Untersuchung oder eine Behandlung Patientinnen und Patienten schadet, indem etwa ihre Lebensqualität verringert oder ihr Leben verkürzt wird. Wir unterscheiden „geringen“ und „erheblichen“ Schaden, wobei dabei sowohl Größe als auch Häufigkeit des Schadens berücksichtigt werden. Bei Vorsorge-, Früherkennungsuntersuchungen und invasiven Behandlungen gehen wir auch ohne Studien grundsätzlich von „Hinweisen auf einen geringen Schaden“ aus.
"Eine „Studie“ ist eine wissenschaftliche Untersuchung. Eine klinische Studie testet die Wirksamkeit von medizinischen Verfahren oder Medikamenten an Patientinnen und Patienten. Studien durchlaufen verschiedene Phasen und und kommen in unterschiedlichen Qualitätsstufen vor. Die höchste Qualität und damit Aussagekraft wird einer Studie zugesprochen, bei der die Studienteilnehmenden zufällig auf zwei Gruppen verteilt werden, von denen die eine mit dem Verfahren untersucht oder behandelt wird und die andere als Kontrolle dient. Diese Studien nennt man „randomisierte kontrollierte Studien„ oder kurz RCT.
"Eine „Studie“ ist eine wissenschaftliche Untersuchung. Eine klinische Studie testet die Wirksamkeit von medizinischen Verfahren oder Medikamenten an Patientinnen und Patienten. Studien durchlaufen verschiedene Phasen und und kommen in unterschiedlichen Qualitätsstufen vor. Die höchste Qualität und damit Aussagekraft wird einer Studie zugesprochen, bei der die Studienteilnehmenden zufällig auf zwei Gruppen verteilt werden, von denen die eine mit dem Verfahren untersucht oder behandelt wird und die andere als Kontrolle dient. Diese Studien nennt man „randomisierte kontrollierte Studien„ oder kurz RCT.
"Eine „Studie“ ist eine wissenschaftliche Untersuchung. Eine klinische Studie testet die Wirksamkeit von medizinischen Verfahren oder Medikamenten an Patientinnen und Patienten. Studien durchlaufen verschiedene Phasen und und kommen in unterschiedlichen Qualitätsstufen vor. Die höchste Qualität und damit Aussagekraft wird einer Studie zugesprochen, bei der die Studienteilnehmenden zufällig auf zwei Gruppen verteilt werden, von denen die eine mit dem Verfahren untersucht oder behandelt wird und die andere als Kontrolle dient. Diese Studien nennt man „randomisierte kontrollierte Studien„ oder kurz RCT.
"Eine „Übersichtsarbeit“ wird auch als „Review“ bezeichnet. Unterschieden werden unsystematische Reviews, die mehrere Originalartikel meist über klinische Studien zitieren, und systematische Reviews, die transparent darlegen, wie sie Artikel gesucht haben und wie sie die einzelnen Artikel bewerten. Systematische Reviews können sehr hilfreich sein, weil sie den bestmöglichen Überblick über die Studienlage geben.
"Eine „Übersichtsarbeit“ wird auch als „Review“ bezeichnet. Unterschieden werden unsystematische Reviews, die mehrere Originalartikel meist über klinische Studien zitieren, und systematische Reviews, die transparent darlegen, wie sie Artikel gesucht haben und wie sie die einzelnen Artikel bewerten. Systematische Reviews können sehr hilfreich sein, weil sie den bestmöglichen Überblick über die Studienlage geben.
"